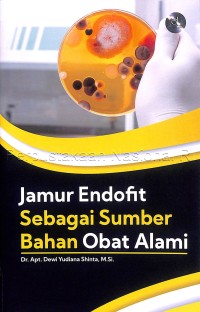
Jamur endofit sebagai sumber bahan obat alami

Text
Jamur endofit sebagai sumber bahan obat alami
Deskripsi
Sinopsis Buku Jamur Endofit sebagai Sumber Bahan Obat Alami
Buku Jamur Endofit sebagai Sumber Bahan Obat Alami
Kata “endofit” berasal dari bahasa Yunani, “endo” yang berarti “di dalam” dan “fit” (phyte) yang berarti tumbuhan (Agusta, 2009). Mikroba endofit menurut Kumala (2006) adalah mikroba yang seluruh atau sebagian hidupnya berada dalam jaringan hidup tanaman inang tanpa menimbulkan gejala yang merugikan bagi tanaman inang itu sendiri. Mikroba seperti kapang, khamir, dan bakteri dapat berasosiasi dengan tanaman dan membantu proses metabolisme tanaman inang untuk menghasilkan metabolit sekunder yang potensial.
Mikroba endofit sendiri terdiri atas bakteri, fungi atau jamur, dan aktinomisetes. Untuk mikroba jenis ini, golongan yang paling banyak ditemukan adalah fungi dan aktinomisetes. Mikroba endofit dikenal sebagai senyawa antimikroba yang secara aktif dapat membunuh mikroba-mikroba patogen sehingga berhasil mencuri perhatian besar karena kemampuannya menghasilkan senyawa bioaktif yang berpotensi sebagai antibiotik ini. Mikroba endofit, di samping itu, juga mampu menghasilkan senyawa-senyawa yang berpotensi sebagai antikanker, antimalaria, anti-HIV, dan antioksidan (Prihatiningtias, 2007 dan Purwanto, 2008).
Buku ini disajikan dengan susunan yang sistematis dan penyampaian yang mudah dipahami. Isi buku terdiri atas 8 bab yang mencakup materi mengenai mikroba endofit, senyawa obat umbi tanaman dahlia, proses fermentasi dan jamur, senyawa metabolit sekunder, lingkungan hidup, relevansi riset, kerangka pemikiran, dan juga hipotesis. Kami berharap semoga buku ini dapat menjadi salah satu referensi bagi para pembaca, khususnya bagi kaum akademisi yang sedang berkecimpung dalam bidang yang sama, maupun bagi para pembaca pada umumnya yang tertarik untuk menambah pengetahuan mengenai jamur endofit.
Ketersediaan
| 1905056 | 632.4 DEW j | Tersedia - Indonesia | |
| 1905055 | 632.4 DEW j | Tersedia - Indonesia |
Informasi Detail
- Judul Seri
-
-
- No. Panggil
-
632.4 DEW j
- Penerbit
- Yogyakarta : deepublish., 2021
- Deskripsi Fisik
-
vi, 43 halaman : ilustrasi ; 23 cm
- Bahasa
-
Indonesia
- ISBN/ISSN
-
978-623-02-2645-8
- Klasifikasi
-
632.4
- Tipe Isi
-
-
- Tipe Media
-
-
- Tipe Pembawa
-
-
- Edisi
-
cet 1
- Subjek
-
-
- Info Detail Spesifik
-
-
- Pernyataan Tanggungjawab
-
-
Versi lain/terkait
Tidak tersedia versi lain
Lampiran Berkas
Komentar
Anda harus masuk sebelum memberikan komentar




























 Karya Umum
Karya Umum  Filsafat
Filsafat  Agama
Agama  Ilmu-ilmu Sosial
Ilmu-ilmu Sosial  Bahasa
Bahasa  Ilmu-ilmu Murni
Ilmu-ilmu Murni  Ilmu-ilmu Terapan
Ilmu-ilmu Terapan  Kesenian, Hiburan, dan Olahraga
Kesenian, Hiburan, dan Olahraga  Kesusastraan
Kesusastraan  Geografi dan Sejarah
Geografi dan Sejarah